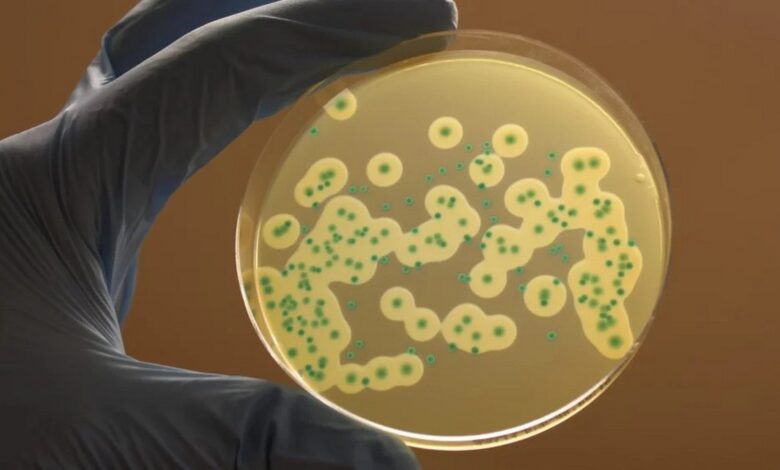

Молоко, колбаса, мыши, клещи – что общего в этих словах? Однозначно – листериоз. Что это за заболевание, как оно проявляется и чем опасно, а также как его избежать, рассказала завотделением особо опасных инфекций с санитарно-карантинным пунктом Минского городского центра гигиены и эпидемиологии, врач-эпидемиолог Любовь Шепелевич.

Что такое листериоз
Это инфекционное заболевание, которое отличается клиническим полиморфизмом (разнообразием симптомов). Может быть как латентным (без внешних проявлений), так и приводящим к тяжелым поражениям нервной системы, сепсису и высокой летальности.
Заражаются листериозом в основном беременные, новорожденные и люди с угнетенным иммунитетом. Опасен он также для животных.
Основной возбудитель заболевания − грамположительная бактерия Listeria monocytogenes.
Источники листериоза у человека

Источниками инфекции выступают больные и переболевшие животные, а также являющиеся носителями бактерии. Опасные распространители листериоза – дикие и синантропные (обитающие в жилищах, подсобных помещениях и постройках человека) грызуны, загрязняющие своими зараженными выделениями воду, корма для скота.
Свою лепту в поддержание очага инфекции вносят кровососущие насекомые (особенно клещи), переносящие бактерию от больных к здоровым особям, способствуя поражению домашних и сельскохозяйственных животных, птицы.
Механизмы передачи возбудителя инфекции:
- фекально-оральный (когда заражение происходит в основном через грязные руки, в том числе после игр с животными или работы с землей, а также через загрязненную воду, продукты питания),
- контактный (когда инфекция передается при рукопожатиях, объятиях или через предметы),
- аспирационный (при вдыхании воздуха во время переработки зерна, при перекладке сена или соломы, в которых побывали больные грызуны, а также во время уборки помещений, где есть следы жизнедеятельности грызунов),
- трансплацентарный (заражение ребенка от матери через плаценту в период беременности).
Чаще всего заболеть можно при употреблении в пищу сырых продуктов или недостаточно обработанных термически. Это, к примеру, сырое молоко, мягкие сыры, сливочное масло домашнего или фабричного изготовления, мороженое.
Мясо и мясные продукты (в том числе из птицы), фарш, сосиски, хот-доги, сыровяленые и сыровареные колбасы, особенно в вакуумных упаковках. А также рыба и морепродукты, в которых произошло накопление листерий.
Из овощей – квашеная капуста, редис, морковь, салаты, в том числе острые (корейские), винегреты.
Не исключено попадание возбудителя в организм человека при заглатывании или питье загрязненной воды (при купании в водоемах, употреблении воды из нецентрализованных источников).
Следует быть начеку тем, кто имеет дело с обработкой животного сырья (шерсти, щетины, кожи, шкуры, пера, пуха). Заражение может произойти аспирационным (аэрогенным, воздушным) способом.
Также листерии могут попадать в организм человека через порезы и ссадины на коже. Это актуально для представителей профессий, имеющих контакты с больными животными (листерионосителями) или продуктами животного происхождения: работников ветеринарных клиник, мясокомбинатов и животноводческих ферм.
Жизнестойкость листерий

Листерии весьма устойчивы к внешнему воздействию. Они не только выживают, но и размножаются при температуре от -1,5 0С до +44 0С.
L. monocytogenes выживают при нагревании до +75 °С и не гибнут при замораживании до -180 0С. Бактерии неплохо себя чувствуют в различных кислотных средах (рН 4,4-11,0) и в растворах, содержащих до 20% поваренной соли. Выдерживают высушивание, присутствие фенольных соединений коптильного дыма и не погибают при пастеризации и варке колбасных изделий.
Чем больше в мясе соединительной ткани, тем ниже термоустойчивость листерий. В то время как жир пищевых продуктов оказывает на них защитное действие.
В мясе и шкурах, консервированных хлористым натрием, возбудитель листериоза сохраняется 60 суток и более.
Во влажной среде бактерии способны жить месяцами, в пыли – до двух лет.
Как развивается заболевание? Признаки

Инкубационный период и клинические проявления листериоза зависят от целого ряда факторов: способа попадания микроба в организм человека, реакции иммунной системы, возраста, пола, сопутствующих заболеваний и т.д.
Так, с момента появления возбудителя в организме до проявления первых симптомов заболевания может пройти от 1-2 дней до 2-4 недель, изредка до 1,5-2 месяцев.
Проявляется недуг внезапно: повышается температура тела, возникают озноб, головная и мышечная боль, нередко – сыпь, особенно в области крупных суставов. Пропадает аппетит, нарастают бессонница и раздражительность.
В начале этого текста мы говорили о полиморфизме, который объясняется включением в процесс отдельных органов и систем.
Признаками листериоза могут быть:
- шейные и подмышечные лимфоузлы, увеличенные и болезненные,
- ригидность затылочных мышц (рефлекторное сопротивление скованных напряжением мышц в ответ на попытку пригнуть голову больного к груди),
- тошнота, рвота,
- учащенный стул,
- боли в животе (схваткообразные),
- симптомы менингита,
- симптомы энцефалита,
- увеличенные печень и селезенка.
Чем опасен листериоз у беременных

К сожалению, у беременных правильный диагноз нередко устанавливается постфактум, ретроспективно.
О листериозе у беременных могут свидетельствовать следующие признаки:
- симптомы ОРВИ (в т.ч. кратковременная лихорадка и боли в мышцах),
- симптомы ангины,
- конъюнктивит,
- симптомы гастроэнтерита (диарея, рвота и боль в животе),
- симптомы пиелита (острые боли в области поясницы, болезненное и учащенное мочеиспускание),
Заболевание также может протекать бессимптомно, и это тоже усложняет постановку диагноза.
Листериоз у беременных может привести к:
- досрочному прерыванию беременности,
- привычному невынашиванию (самопроизвольному выкидышу),
- порокам развития плода,
- внутриутробной гибели плода.
Помимо возможной гибели плода, листериоз является причиной высокой летальности новорожденных (50% и выше).
Где распространено заболевание?

С конца 80-х гг. XX ст. и в начале нынешнего века были зафиксированы крупные вспышки листериоза у жителей Западной Европы (Франции, Великобритании, Швейцарии, Финляндии) и Северной Америки (США, Канады).
Количество заболевших варьировалось от нескольких десятков до нескольких сотен человек. Как правило, причиной заражения стало употребление продуктов животного и растительного происхождения, а также морепродуктов.
В 2022 году в 10 штатах США зарегистрировано 23 случая заболевания листериозом, в том числе один смертельный. Доказано, что возбудитель содержался в мороженом.
В Италии в результате вспышки листериоза пострадало более 60 человек, из которых троих спасти не удалось. При расследовании листерия была обнаружена в сосисках из мяса птицы.
В Норвегии копченый лосось стал причиной заражения четырех человек.
По оценкам Центра по контролю и профилактике заболеваний США, ежегодно в мире листериозом заболевают около 1600 человек, и около 260 из них умирают.
Любовь Шепелевич:
– В Республике Беларусь регистрируются единичные случаи этого недуга: за истекший период 2022 и 2021 годов – по 8 случаев. В Минске в 2021 году было трое заболевших, за 2022 год – четверо. 70 % из них старше 50 лет, при этом имели сопутствующую патологию (заболевания сердечно-сосудистой системы, сахарный диабет, вторичный иммунодефицит). В 100 % отмечено тяжелое течение заболевания (листериозный менингоэнцефалит).
По словам эксперта, содержащая возбудитель заражения мясная продукция (как полуфабрикаты, так и готовая к употреблению) была приобретена в торговой сети. Однако треть заболевших употребляли в пищу плодовоовощную продукцию, самостоятельно выращенную на приусадебных участках, где возможен контакт с грызунами и продуктами их жизнедеятельности.
Профилактика листериоза

Как правильно хранить продукты и готовить пищу, чтобы не свести риск заражения к минимуму?
Вот несколько основных правил:
- приобретайте и употребляйте только качественные продукты, без признаков порчи;
- овощи и фрукты, которые будут использованы в пищу сырыми, отбирайте и мойте особенно тщательно;
- для сырых и термически обработанных продуктов нужны разные ножи, посуда, разделочные доски;
- хранить готовые к употреблению блюда и сырые ингредиенты (мясо, птица, яйца, рыба, овощи и фрукты) следует также отдельно;
- продукты животного происхождения (мясо, птицу и т.д.) необходимо варить, жарить, тушить до полной готовности;
- воду для питья используйте только кипяченую либо бутилированную, фасованную в заводской упаковке;
- помещение, где хранятся пищевые продукты, защищайте от проникновения грызунов и насекомых.
Особенно внимательно выбирайте молочные продукты, включая мягкий сыр, мороженое и йогурт: они должны быть изготовлены из пастеризованного молока (ищите информацию об этом на этикетке). Это касается в первую очередь людей с ослабленным иммунитетом и пожилых, беременных женщин и родителей, покупающих молочные продукты для младенцев и детей младшего возраста.
Будьте осторожны и с копченой рыбой – следует употреблять в пищу только консервы, исключить из меню рыбу холодного копчения или использовать ее в готовом блюде после достаточной термической обработки, рекомендует наш эксперт.
При любом подозрении на листериоз немедленно обратитесь к врачу.
Источник: 24health.by
